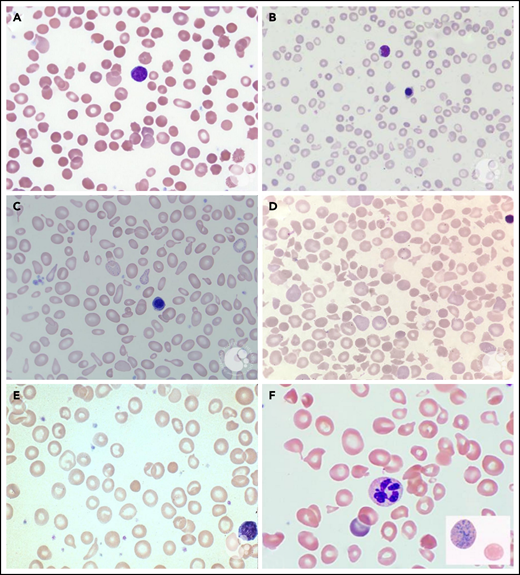
PB smears. PB smears from (A) hereditary spherocytosis. Dense, spherical-shaped erythrocytes are seen. (B) β-Thalassemia major. Hypochromic, microcytic erythrocytes, anisocytosis, and a nucleated red blood cell are seen. (C) Sideroblastic anemia. Polychromasia, anisopoikilocytosis, and basophilic stippling are seen in a case of X-linked congenital sideroblastic anemia. (D) Thrombotic thrombocytopenic purpura. Anisopoikilocytosis and marked schistocytosis are seen on the smear of an infant with Upshaw-Schulman syndrome. (E) Iron deficiency. Significant anisocytosis, hypochromia, and microcytosis are seen. (F) Vitamin B12 deficiency. Macro-ovalocytes, microcytes, and hypersegmented neutrophils are seen. Erythrocyte basophilic stippling is shown in inset. These images were originally published in the ASH Image Bank. (A) Teresa Scordino, Hereditary spherocytosis, 2016, #00060308. (B) Girish Venkataraman, β-thalassemia major, 2018, #00062081; (C) Katherine Calvo, Congenital sideroblastic anemia peripheral blood, 2015; #00060064; (D) Helle Borgstrøm Hager and Mari Tjernsmo Andersen, Thrombotic thrombocytopenic purpura, #00061402; (E) Iron deficiency anemia moderate, 2015, #00060219. (F) Volodymyr Shponka and Maria Proytcheva, Megaloblastic anemia caused by severe B12 deficiency in a breastfed infant. 2017, #00061082. © The American Society of Hematology.

Key Points
Anemia is a major global burden, affecting almost 2 billion people worldwide, particularly infants and young children.
Population approaches are being employed to treat dietary anemia, and therapeutic advances are improving care for inherited anemias.
Abstract
The World Health Organization estimates that approximately a quarter of the world’s population suffers from anemia, including almost half of preschool-age children. Globally, iron deficiency anemia is the most common cause of anemia. Other important causes of anemia in children are hemoglobinopathies, infection, and other chronic diseases. Anemia is associated with increased morbidity, including neurologic complications, increased risk of low birth weight, infection, and heart failure, as well as increased mortality. When approaching a child with anemia, detailed historical information, particularly diet, environmental exposures, and family history, often yield important clues to the diagnosis. Dysmorphic features on physical examination may indicate syndromic causes of anemia. Diagnostic testing involves a stepwise approach utilizing various laboratory techniques. The increasing availability of genetic testing is providing new mechanistic insights into inherited anemias and allowing diagnosis in many previously undiagnosed cases. Population-based approaches are being taken to address nutritional anemias. Novel pharmacologic agents and advances in gene therapy-based therapeutics have the potential to ameliorate anemia-associated disease and provide treatment strategies even in the most difficult and complex cases.
Introduction
Anemia is the most common hematologic abnormality identified in infants and children. Approximately a quarter of the world’s population suffers from anemia, almost 2 billion people, with almost half of children <5 years of age affected in 2016.1 Anemia is associated with increased morbidity and mortality in children, particularly children of preschool age. There are many causes of anemia, both inherited and acquired, and these causes vary widely in populations across the world. Anemia is not a specific disease entity per se but represents a heterogeneous group of pathologic conditions. Anemia is defined quantitatively as a decreased number of circulating erythrocytes or functionally as a condition where numbers of erythrocytes, carriers of oxygen, are insufficient to meet metabolic demands. In practice, anemia is defined by hemoglobin (Hb), hematocrit, or red blood cell count levels lower than the normal age- and sex-adjusted ranges.
Use of appropriate ranges when defining anemia is important.2,3 Throughout the first year of life, erythrocytes lose their fetal and neonatal characteristics, changing globin composition, metabolism, size, volume, membrane structure, and function. These changes are reflected by decreases in Hb, as well as mean corpuscular volume (MCV), mean corpuscular Hb (MCH), and mean corpuscular Hb concentration (MCHC) (Table 1). Hb levels gradually increase during childhood then level off during adulthood.1 After puberty, gender differences occur due to menstruation and subsequent iron loss in females (Figure 1). Other factors influence Hb levels, such as diet, living at high altitudes, or smoking. Normalized Hb value curves have been developed for children living at high altitudes.4 In addition, genome-wide association studies have revealed individual genetic variation contributes to differences in erythrocyte indices.5
Normal hematologic values during the first year of life in healthy term infants*
| . | Age (mo) . | ||||||
|---|---|---|---|---|---|---|---|
| . | 0.5 (n = 232) . | 1 (n = 240) . | 2 (n = 241) . | 4 (n = 52) . | 6 (n = 52) . | 9 (n = 56) . | 12 (n = 56) . |
| Hb (g/dL, mean ± SE), (−2 SD) | 16.6 ± 6 0.11 (13.4) | 13.9 ± 0.10 (10.7) | 11.2 ± 0.06 (9.4) | 12.2 ± 0.14 (10.3) | 12.6 ± 0.10 (11.1) | 12.7 ± 0.09 (11.4) | 12.7 ± 0.09 (11.3) |
| Hematocrit (%, mean ± SE), (−2 SD) | 53 ± 0.4 (41) | 44 ± 0.3 (33) | 35 ± 0.2 (28) | 38 ± 0.4 (32) | 36 ± 0.3 (31) | 36 ± 0.3 (32) | 37 ± 0.3 (33) |
| RBC count (×1012/L, mean ± SE), (−2 SD + 2 SD) | 4.9 ± 0.03 (3.9-5.9) | 4.3 ± 0.03 (3.3-5.3) | 3.7 ± 0.02 (3.1-4.3) | 4.3 ± 0.06 (3.5-5.1) | 4.7 ± 0.05 (3.9-5.5) | 4.7 ± 0.04 (4.0-5.3) | 4.7 ± 0.04 (4.1-5.3) |
| MCH (pg, mean ± SE), (−2 SD) | 33.6 ± 0.1 (30) | 32.5 ± 0.1 (29) | 30.4 ± 0.1 (27) | 28.6 ± 0.2 (25) | 26.8 ± 0.2 (24) | 27.3 ± 0.2 (25) | 26.8 ± 0.2 (24) |
| MCV (fL, mean ± SE), (−2 SD) | 105.3 ± 0.6 (88) | 101.3 ± 0.3 (91) | 94.8 ± 0.3 (84) | 86.7 ± 0.8 (76) | 76.3 ± 0.6 (68) | 77.7 ± 0.5 (70) | 77.7 ± 0.5 (71) |
| MCHC (g/dL, mean ± SE), (−2 SD) | 314 ± 1.1 (281) | 318 ± 1.2 (281) | 318 ± 1.1 (283) | 327 ± 2.7 (288) | 350 ± 1.7 (327) | 349 ± 1.6 (324) | 343 ± 1.5 (321) |
| . | Age (mo) . | ||||||
|---|---|---|---|---|---|---|---|
| . | 0.5 (n = 232) . | 1 (n = 240) . | 2 (n = 241) . | 4 (n = 52) . | 6 (n = 52) . | 9 (n = 56) . | 12 (n = 56) . |
| Hb (g/dL, mean ± SE), (−2 SD) | 16.6 ± 6 0.11 (13.4) | 13.9 ± 0.10 (10.7) | 11.2 ± 0.06 (9.4) | 12.2 ± 0.14 (10.3) | 12.6 ± 0.10 (11.1) | 12.7 ± 0.09 (11.4) | 12.7 ± 0.09 (11.3) |
| Hematocrit (%, mean ± SE), (−2 SD) | 53 ± 0.4 (41) | 44 ± 0.3 (33) | 35 ± 0.2 (28) | 38 ± 0.4 (32) | 36 ± 0.3 (31) | 36 ± 0.3 (32) | 37 ± 0.3 (33) |
| RBC count (×1012/L, mean ± SE), (−2 SD + 2 SD) | 4.9 ± 0.03 (3.9-5.9) | 4.3 ± 0.03 (3.3-5.3) | 3.7 ± 0.02 (3.1-4.3) | 4.3 ± 0.06 (3.5-5.1) | 4.7 ± 0.05 (3.9-5.5) | 4.7 ± 0.04 (4.0-5.3) | 4.7 ± 0.04 (4.1-5.3) |
| MCH (pg, mean ± SE), (−2 SD) | 33.6 ± 0.1 (30) | 32.5 ± 0.1 (29) | 30.4 ± 0.1 (27) | 28.6 ± 0.2 (25) | 26.8 ± 0.2 (24) | 27.3 ± 0.2 (25) | 26.8 ± 0.2 (24) |
| MCV (fL, mean ± SE), (−2 SD) | 105.3 ± 0.6 (88) | 101.3 ± 0.3 (91) | 94.8 ± 0.3 (84) | 86.7 ± 0.8 (76) | 76.3 ± 0.6 (68) | 77.7 ± 0.5 (70) | 77.7 ± 0.5 (71) |
| MCHC (g/dL, mean ± SE), (−2 SD) | 314 ± 1.1 (281) | 318 ± 1.2 (281) | 318 ± 1.1 (283) | 327 ± 2.7 (288) | 350 ± 1.7 (327) | 349 ± 1.6 (324) | 343 ± 1.5 (321) |
Values at the ages of 0.5, 1, and 2 mo were obtained from the entire group, and those at the later ages were obtained from the iron supplemented infant group after exclusion of iron deficiency.121
These values were obtained from a selected group of 256 healthy term infants followed at the Helsinki University Central Hospital who were receiving continuous iron supplementation and who had normal values for transferrin saturation and serum ferritin.
Mean Hb concentrations by age and sex (−2 SD values). Compiled from data from the United States, Europe, and White populations. Used with permission from Chaparro and Suchdev.1
Mean Hb concentrations by age and sex (−2 SD values). Compiled from data from the United States, Europe, and White populations. Used with permission from Chaparro and Suchdev.1
Classification of anemia
Anemia can be classified in many ways, such as congenital or acquired, acute or chronic, hemolytic or nonhemolytic, based on peripheral blood (PB) smear findings, or based on erythrocyte size. Hemolytic anemia may be further classified as inherited or acquired, immune or nonimmune, acute or chronic, whether hemolysis occurs in the vasculature (intravascular) or the reticuloendothelial system (extravascular), and whether there is a cellular defect of the erythrocyte (intrinsic) or extracellular (extrinsic) abnormality. Whereas most intrinsic defects are inherited, such as membrane disorders, metabolic defects, and Hb disorders, most extrinsic defects are acquired, such as immune-mediated anemia, systemic disease, and drug- or toxin-mediated effects. A few disorders, such as paroxysmal nocturnal hemoglobinuria, exhibit intrinsic and extrinsic hemolysis. Table 2 shows some causes of hemolytic anemia.
Etiologies of hemolytic anemia
| Intrinsic hemolysis |
| Hemoglobin disorders |
| α-Thalassemias |
| β-Thalassemias |
| Sickle cell disease |
| Unstable hemoglobins |
| Membrane defects |
| Hereditary spherocytosis |
| Hereditary elliptocytosis, pyropoikilocytosis and related disorders |
| Hereditary stomatocytosis syndromes |
| Xerocytosis |
| Hydrocytosis |
| Rh null syndrome |
| GLUT1 deficiency |
| Tangier disease |
| Abetalipoproteinemia |
| Phytosterolemia |
| Enzymopathies |
| HMP shunt abnormality |
| Glucose-6-phosphate dehydrogenase |
| Embden-Meyerhof defect (glycolysis) |
| Pyruvate kinase |
| Hexokinase |
| Glucose phosphate isomerase |
| Phosphofructokinase |
| Triosephosphate kinase |
| Phosphoglycerate kinase |
| Aldolase |
| Glutathione metabolism defect |
| 5′ nucleotidase deficiency |
| Extrinsic hemolysis |
| Immune mediated |
| Primary |
| Warm-reactive autoimmune hemolytic anemia |
| Alloimmune hemolytic anemia |
| Acute hemolytic transfusion reaction |
| Delayed hemolytic transfusion reaction |
| Drug-induced hemolytic anemias (some types) |
| Secondary |
| Autoimmune or inflammatory disorders |
| Evans syndrome |
| Primary immunodeficiency |
| Wiskott-Aldrich syndrome |
| Common variable immune deficiency |
| Acquired immunodeficiency |
| HIV infection |
| Malignancy |
| Infection |
| Posttransplant |
| Cold agglutinins |
| Primary |
| Secondary |
| Infection (e.g., Mycoplasma, Epstein-Barr virus) |
| Malignancy |
| Lymphoid |
| Nonlymphoid |
| Paroxysmal cold hemoglobinuria |
| Immune |
| Postinfectious |
| Other |
| Recluse spider venom |
| Clostridial sepsis |
| Erythrocyte fragmentation |
| Primary thrombotic microangiopathy (TMA) |
| Inherited |
| ADAMTS13 deficiency/TTP (mutations in ADAMTS13) |
| Complement-mediated (mutations in CFH, CFI, CFB, C3, CD46, etc.) |
| Metabolism mediated (MMACHC mutations) |
| Coagulation-mediated (DGKE, PLG, THBD mutations) |
| Acquired |
| TTP (autoantibody) |
| Shiga toxin-mediated TMA (SH-TTP) |
| Drug-mediated (immune mediated) |
| Drug-mediated (toxic dose-related) |
| Complement-mediated (antibody) |
| Systemic disorders |
| DIC, many causes |
| HELLP syndrome |
| Malignancy |
| Malignant hypertension |
| Scleroderma renal crisis |
| Antiphospholipid syndrome |
| Infection |
| Complicated malaria |
| Clostridia or Haemophilus influenzae type b |
| Isolated intravascular sites of hemolysis |
| Kasabach-Merritt syndrome |
| Renal artery stenosis |
| Large vessel thrombi |
| Severe aortic coarctation |
| TIPS |
| Vasculitis |
| Dysfunctional cardiac valves or cardiac assist devices |
| March hemoglobinuria, extreme running |
| Other mechanical causes |
| Heat denaturation (blood warmer, thermal burns) |
| Osmotic stress |
| Drowning |
| Mechanical trauma |
| March hemoglobinuria |
| Marathon runners, etc. |
| Direct trauma |
| “Cell saver” devices |
| Thrombectomy |
| Cardiac bypass |
| Extracorporeal membrane oxygenation |
| Dialysis |
| Hypersplenism |
| Intrinsic hemolysis |
| Hemoglobin disorders |
| α-Thalassemias |
| β-Thalassemias |
| Sickle cell disease |
| Unstable hemoglobins |
| Membrane defects |
| Hereditary spherocytosis |
| Hereditary elliptocytosis, pyropoikilocytosis and related disorders |
| Hereditary stomatocytosis syndromes |
| Xerocytosis |
| Hydrocytosis |
| Rh null syndrome |
| GLUT1 deficiency |
| Tangier disease |
| Abetalipoproteinemia |
| Phytosterolemia |
| Enzymopathies |
| HMP shunt abnormality |
| Glucose-6-phosphate dehydrogenase |
| Embden-Meyerhof defect (glycolysis) |
| Pyruvate kinase |
| Hexokinase |
| Glucose phosphate isomerase |
| Phosphofructokinase |
| Triosephosphate kinase |
| Phosphoglycerate kinase |
| Aldolase |
| Glutathione metabolism defect |
| 5′ nucleotidase deficiency |
| Extrinsic hemolysis |
| Immune mediated |
| Primary |
| Warm-reactive autoimmune hemolytic anemia |
| Alloimmune hemolytic anemia |
| Acute hemolytic transfusion reaction |
| Delayed hemolytic transfusion reaction |
| Drug-induced hemolytic anemias (some types) |
| Secondary |
| Autoimmune or inflammatory disorders |
| Evans syndrome |
| Primary immunodeficiency |
| Wiskott-Aldrich syndrome |
| Common variable immune deficiency |
| Acquired immunodeficiency |
| HIV infection |
| Malignancy |
| Infection |
| Posttransplant |
| Cold agglutinins |
| Primary |
| Secondary |
| Infection (e.g., Mycoplasma, Epstein-Barr virus) |
| Malignancy |
| Lymphoid |
| Nonlymphoid |
| Paroxysmal cold hemoglobinuria |
| Immune |
| Postinfectious |
| Other |
| Recluse spider venom |
| Clostridial sepsis |
| Erythrocyte fragmentation |
| Primary thrombotic microangiopathy (TMA) |
| Inherited |
| ADAMTS13 deficiency/TTP (mutations in ADAMTS13) |
| Complement-mediated (mutations in CFH, CFI, CFB, C3, CD46, etc.) |
| Metabolism mediated (MMACHC mutations) |
| Coagulation-mediated (DGKE, PLG, THBD mutations) |
| Acquired |
| TTP (autoantibody) |
| Shiga toxin-mediated TMA (SH-TTP) |
| Drug-mediated (immune mediated) |
| Drug-mediated (toxic dose-related) |
| Complement-mediated (antibody) |
| Systemic disorders |
| DIC, many causes |
| HELLP syndrome |
| Malignancy |
| Malignant hypertension |
| Scleroderma renal crisis |
| Antiphospholipid syndrome |
| Infection |
| Complicated malaria |
| Clostridia or Haemophilus influenzae type b |
| Isolated intravascular sites of hemolysis |
| Kasabach-Merritt syndrome |
| Renal artery stenosis |
| Large vessel thrombi |
| Severe aortic coarctation |
| TIPS |
| Vasculitis |
| Dysfunctional cardiac valves or cardiac assist devices |
| March hemoglobinuria, extreme running |
| Other mechanical causes |
| Heat denaturation (blood warmer, thermal burns) |
| Osmotic stress |
| Drowning |
| Mechanical trauma |
| March hemoglobinuria |
| Marathon runners, etc. |
| Direct trauma |
| “Cell saver” devices |
| Thrombectomy |
| Cardiac bypass |
| Extracorporeal membrane oxygenation |
| Dialysis |
| Hypersplenism |
One clinically useful classification based on MCV and reticulocyte count (Figure 2) initially classifies anemias as microcytic, normocytic, and macrocytic based on MCV, then further refines the differential diagnoses based on the reticulocyte count. This classification scheme will be used to review etiologies of anemia in infants and children.
An approach to anemia based on mean corpuscular volume and reticulocyte count.
Approach to the anemic child
Diagnostic evaluation of the anemic child combines history, physical examination, and laboratory investigation.
History and physical
Patient and family history often reveal important clues to the etiology of anemia. Review of birth history should include labor, delivery, and neonatal course, including the history of anemia, jaundice, phototherapy, or blood transfusion. History of other medical issues and medication use should be elicited. History of trauma, infections, surgery, travel, and exposure to drugs, chemicals, toxins, or oxidants should be sought, as should sources of blood loss such as epistaxis, gastrointestinal (GI) bleeding, or in young women, dysmenorrhea. Dietary history should include a review of growth and food intake focusing on key nutrients such as iron, folate, vitamin B12, and in infants, milk intake. The age of the patient should be considered as different disorders are common in different age groups (Figure 3).
A family medical review should include the history of anemia, jaundice, splenomegaly, gallstones, blood or autoimmune diseases, bleeding disorders, splenectomy, or cholecystectomy.
Physical findings often reflect the timing, severity, and type of anemia. When anemia is severe and acute, patients are in distress with tachypnea, tachycardia, pallor, and poor perfusion. Other findings may include a systolic ejection heart murmur, distended neck veins, wheezing, and hepatomegaly. If anemia is chronic, pallor or jaundice may be prominent findings. Jaundice, scleral icterus, and splenomegaly may be present in either acute or chronic anemia. Petechiae, ecchymoses, and purpura may provide clues to the diagnosis. Findings of dysmorphic features, especially craniofacial and limb abnormalities, or signs of systemic disease suggest features of one of the genetic syndromes associated with anemia. Significant vascular abnormalities may indicate localized coagulopathy.
Clinical manifestations
The delivery of oxygen throughout the body is the primary role of the erythrocyte. When anemia develops and tissue oxygen is compromised, the body compensates in several ways, including increasing erythropoietin production to increase red blood cell production, increasing erythrocyte 2,3-diphosphoglycerate, reducing oxygen affinity, and shifting the oxygen dissociation curve to the right to enhance erythrocyte release of oxygen to the tissues, increasing cardiac output, and selectively shunting blood to vital organs.6
Symptoms and signs vary based on the duration and severity of anemia. Patients with acute, severe anemia are overtly symptomatic with hypoxia, hypovolemic shock, congestive heart failure, and seizures which may lead to death. Common findings in chronic anemia include pallor, dyspnea, fatigue, exercise intolerance, dizziness, anorexia, and syncope. If there is hemolysis, jaundice and dark urine may be present. In young children, chronic anemia may lead to poor growth and failure to thrive, and if there is iron deficiency or iron deficiency anemia, affects on neurocognitive and behavioral development. Patients with mild to moderate chronic anemia are sometimes asymptomatic relative to the degree of anemia as compensatory mechanisms have had time to be activated.
Laboratory investigation
Initial basic laboratory evaluation includes a complete blood count (CBC), examination of a PB smear, reticulocyte count, direct antiglobulin test (DAT), and serum bilirubin determination. CBC allows assessment of the anemia and identifies whether there are concomitant alterations in leukocyte and platelet counts to suggest a disorder not confined to the erythrocyte lineage or indicating systemic illness. Examination of erythrocyte indices may give clues to the diagnosis; for instance, microcytosis in an anemic infant may suggest the presence of a hemoglobinopathy or iron deficiency, whereas an elevated mean corpuscular Hb concentration may suggest a disorder of the erythrocyte membrane such as hereditary spherocytosis. The PB smear may provide insights into the diagnosis such as spherocytes in hereditary spherocytosis or autoimmune hemolytic anemia, elliptocytes in hereditary elliptocytosis, fragmented cells, schistocytes, and helmet cells in microangiopathic hemolytic anemia, target cells in hemoglobinopathies, liver disease, and post-splenectomy, and inclusions of various types seen in malaria or babesiosis. Red cell distribution width is a measure of the size and volume of populations of circulating erythrocytes. When used with other indices, it may provide clues to the diagnosis, such as thalassemia. Reticulocyte Hb concentration is included on many cell counters, providing information on iron status.
An elevated reticulocyte count indicates increased erythropoietic response to blood loss or hemolysis, whereas a low reticulocyte count, especially relative to the degree of anemia, indicates inadequate erythropoietic response. A positive DAT test suggests immune-mediated hemolysis. The presence of anemia with findings of hemolysis on PB smear and hyperbilirubinemia in a child with a negative DAT suggests an intrinsic erythrocyte defect. The child with acute onset normocytic, normochromic nonhemolytic anemia and a negative DAT test should be suspected of having had acute blood loss. Additional diagnostic evaluation is indicated. The use of a diagnostic algorithm may facilitate evaluation (Figure 2).
The utilization of DNA sequencing methodologies has greatly improved the accuracy of precise genetic diagnosis in many cases of inherited anemias.7,8 Now available from commercial laboratories, various diagnostic strategies, including targeted gene capture, gene panels, and whole-exome sequencing, have been used as effective tools for identification of disease-causing mutations. Genetic testing has allowed new mechanistic insights into many inherited anemias and provided the answer in many previously undiagnosed cases. Current molecular genetic analyses have potential pitfalls, including detecting variants of unknown significance, making genetic diagnosis uncertain in some cases, and the inability to detect mutations in distant regulatory elements, deep intronic splicing mutations, and intragenic deletions.9 Whole genome sequencing, employed primarily on a research basis to date, has provided the precise genetic diagnosis in some cases.10
Normocytic anemia
Many pediatric anemias are associated with normocytic erythrocyte indices, MCV 80-100 fL.
Normocytic anemia with elevated reticulocyte count
This large group of pediatric anemias includes inherited disorders of the erythrocyte membrane, cellular metabolism, and unstable Hbs, as well as acquired disorders including immune hemolysis and microangiopathic disorders such as hemolytic uremic syndrome, thrombotic thrombocytopenic purpura, and disseminated intravascular coagulation.
A hallmark of many of these disorders is hemolysis, premature breakdown of erythrocytes. Mechanisms of hemolysis include poor deformability of the erythrocyte leading to splenic trapping and subsequent phagocytosis, antibody-mediated destruction through phagocytosis or direct complement activation, fragmentation due to microthrombi or direct mechanical trauma, oxidation, or direct cellular destruction. Hemolysis can be classified in several ways, such as immune or nonimmune and intrinsic or extrinsic. Intrinsic hemolysis is due to intrinsic erythrocyte defects such as disorders of Hb, membrane, or metabolism. Intrinsic hemolysis is typically inherited. Extrinsic hemolysis is associated with disorders outside the erythrocyte, such as autoimmune hemolytic anemia (AIHA), most cases of microangiopathic hemolysis such as thrombotic thrombocytopenic purpura (TTP), infection, mechanical injury, toxins such as lead or copper, and drugs such as penicillins, quinine, quinidine, methyldopa, and clopidogrel. Most cases of extrinsic hemolysis are acquired.
Interestingly, infectious causes of hemolysis may be due to direct action of toxins on the erythrocyte, such as by Clostridium perfringens, by direct invasion and destruction of the erythrocyte by the organism, such as malaria, or by antibody production after viral infection.
Laboratory hallmarks of hemolysis include anemia and reticulocytosis. In cases where there is concomitant nutritional deficiency, marrow dysfunction, toxin exposure, or infection, particularly parvovirus infection, the reticulocyte response may be blunted. The blood smear shows polychromasia, schistocytes, and fragmented forms, which are particularly prominent in cases where there is shear stress or toxin-induced hemolysis. Unconjugated bilirubin, lactate dehydrogenase, and aspartate aminotransferase levels may be elevated. Haptoglobin is often decreased. If hemolysis is intravascular, hemoglobinuria may lead to a positive urine dipstick without red blood cells on microscopy.
Nonimmune hemolysis
Nonimmune hemolysis is associated with intrinsic disorders of the erythrocyte, including membrane abnormalities, defects of metabolism, and unstable Hbs. Microangiopathic hemolysis is associated with hemolytic uremic syndrome, TTP, and disseminated intravascular coagulation (DIC).
Erythrocyte membrane disorders
Disorders of the erythrocyte membrane present at any age, in utero, in the neonatal period, in childhood, and some escape detection until late in life.
Hereditary spherocytosis
The hereditary spherocytosis (HS) syndromes are associated with qualitative or quantitative defects in major erythrocyte membrane proteins, including ankyrin-1, β-spectrin, band 3, α-spectrin, and protein 4.1R.11 Clinical severity ranges from asymptomatic patients with well-compensated HS to severe, transfusion-dependent patients. In about three-quarters of cases, inheritance is autosomal dominant. Most HS patients exhibit mild to moderate hemolytic anemia, with some mild cases exhibiting well-compensated hemolysis without anemia. Severely affected patients may be transfusion-dependent, often exhibiting autosomal recessive inheritance. Diagnosis of HS is straightforward in the child with a positive family history and nonimmune spherocytic hemolytic anemia. PB smear shows variable numbers of spherocytes (Figure 4). Diagnostic testing includes eosin-5-maleimide (EMA) flow cytometry or osmotic fragility (OF) testing. In some cases, EMA binding or OF may be normal. Diagnostic molecular testing is gaining in popularity.
PB smears. PB smears from (A) hereditary spherocytosis. Dense, spherical-shaped erythrocytes are seen. (B) β-Thalassemia major. Hypochromic, microcytic erythrocytes, anisocytosis, and a nucleated red blood cell are seen. (C) Sideroblastic anemia. Polychromasia, anisopoikilocytosis, and basophilic stippling are seen in a case of X-linked congenital sideroblastic anemia. (D) Thrombotic thrombocytopenic purpura. Anisopoikilocytosis and marked schistocytosis are seen on the smear of an infant with Upshaw-Schulman syndrome. (E) Iron deficiency. Significant anisocytosis, hypochromia, and microcytosis are seen. (F) Vitamin B12 deficiency. Macro-ovalocytes, microcytes, and hypersegmented neutrophils are seen. Erythrocyte basophilic stippling is shown in inset. These images were originally published in the ASH Image Bank. (A) Teresa Scordino, Hereditary spherocytosis, 2016, #00060308. (B) Girish Venkataraman, β-thalassemia major, 2018, #00062081; (C) Katherine Calvo, Congenital sideroblastic anemia peripheral blood, 2015; #00060064; (D) Helle Borgstrøm Hager and Mari Tjernsmo Andersen, Thrombotic thrombocytopenic purpura, #00061402; (E) Iron deficiency anemia moderate, 2015, #00060219. (F) Volodymyr Shponka and Maria Proytcheva, Megaloblastic anemia caused by severe B12 deficiency in a breastfed infant. 2017, #00061082. © The American Society of Hematology.
PB smears. PB smears from (A) hereditary spherocytosis. Dense, spherical-shaped erythrocytes are seen. (B) β-Thalassemia major. Hypochromic, microcytic erythrocytes, anisocytosis, and a nucleated red blood cell are seen. (C) Sideroblastic anemia. Polychromasia, anisopoikilocytosis, and basophilic stippling are seen in a case of X-linked congenital sideroblastic anemia. (D) Thrombotic thrombocytopenic purpura. Anisopoikilocytosis and marked schistocytosis are seen on the smear of an infant with Upshaw-Schulman syndrome. (E) Iron deficiency. Significant anisocytosis, hypochromia, and microcytosis are seen. (F) Vitamin B12 deficiency. Macro-ovalocytes, microcytes, and hypersegmented neutrophils are seen. Erythrocyte basophilic stippling is shown in inset. These images were originally published in the ASH Image Bank. (A) Teresa Scordino, Hereditary spherocytosis, 2016, #00060308. (B) Girish Venkataraman, β-thalassemia major, 2018, #00062081; (C) Katherine Calvo, Congenital sideroblastic anemia peripheral blood, 2015; #00060064; (D) Helle Borgstrøm Hager and Mari Tjernsmo Andersen, Thrombotic thrombocytopenic purpura, #00061402; (E) Iron deficiency anemia moderate, 2015, #00060219. (F) Volodymyr Shponka and Maria Proytcheva, Megaloblastic anemia caused by severe B12 deficiency in a breastfed infant. 2017, #00061082. © The American Society of Hematology.
Splenectomy used to be performed routinely in the management of HS. Now, due to concerns of sepsis after splenectomy and long-term risks of vascular disease, including pulmonary hypertension, thrombosis risk, and atherosclerosis, its use is currently based on disease severity and symptomatology. Most advocate for splenectomy in HS patients with severe HS who exhibit growth failure, exercise intolerance, skeletal abnormalities, or extramedullary hematopoiesis. In cases of moderate HS, splenectomy should be decided by well-informed patients, their families, and caregivers.
Hereditary elliptocytosis, hereditary pyropoikilocytosis, and related disorders
The hereditary elliptocytosis (HE) syndromes are typically asymptomatic, occurring primarily in individuals of African descent, and are discovered during unrelated laboratory testing. The exceptions are hemolytic HE and the related disorder hereditary pyropoikilocytosis (HPP), when hemolysis, anemia, and jaundice may be severe. HPP is a rare variant of HE. In HPP, hemolysis is severe, the MCV is low (50-65 fl), and the blood smear exhibits erythrocyte morphology reminiscent of that seen in thermal burns with elliptocytes, poikilocytes, pyknocytes, fragmented cells, and microspherocytes.
In both hemolytic HE and HPP, most patients have parents with typical HE and thus are homozygotes or compound heterozygotes for spectrin defects inherited from each of the parents. In many patients, hemolysis abates during infancy, and the clinical picture evolves to typical HE with minimal to no anemia in childhood. In severe cases that do not improve, splenectomy has been successfully used.
Hereditary stomatocytosis syndromes
The hereditary stomatocytosis (HSt) syndromes12 are a heterogeneous group of disorders characterized by abnormal permeability of erythrocytes to sodium and potassium, leading to alterations in water content. Subtypes of HSt have presented in the perinatal period with hydrops fetalis, hemolytic anemia, and hyperbilirubinemia, with others presenting with nonimmune hydrops fetalis unrelated to the degree of fetal anemia. Hereditary xerocytosis has been linked to mutations in the mammalian mechanosensory transduction protein PIEZO1 or the calcium-activated Gardos channel.
Patients present with variable degrees of anemia and few to many stomatocytes on PB smear. In the most common subtype, dehydrated hereditary stomatocytosis, or hereditary xerocytosis, erythrocyte potassium concentration and total monovalent cation content are decreased, reflected in elevated MCHC and MCV and decreased erythrocyte osmotic fragility. Treatment is supportive. Splenectomy is not recommended due to the apparent predisposition to major thromboses after splenectomy. Another unusual manifestation of hereditary xerocytosis is the propensity for iron overload, particularly in adulthood, independent of transfusion history.
Defects of erythrocyte metabolism
Disorders of erythrocyte metabolism comprise a small but important group of inherited disorders. Often termed congenital nonspherocytic hemolytic anemia (CNSHA), this group includes disorders not due to immune-mediated disturbances, thalassemia or sickle cell disease (SCD), or erythrocyte membrane disorders. These include abnormalities of glutathione, nucleotide, or glucose metabolism. Like the HS syndromes, these disorders have significant clinical, laboratory, and genetic heterogeneity. Enzyme or antioxidant deficiency or impaired function leads to hemolysis.
Glucose-6-phosphate dehydrogenase (G6PD) deficiency
The most common metabolic abnormality of the erythrocyte is G6PD deficiency, affecting >400 million people worldwide.13 Its high prevalence is attributed to genetic selection as G6PD-deficient erythrocytes demonstrate a selective advantage against Plasmodium falciparum infection.
In normal erythrocytes, reduced glutathione (GSH) detoxifies intracellular oxidants. In G6PD deficiency, the inability to generate NADPH leads to insufficient amounts of GSH, allowing oxidants free to damage critical erythrocyte proteins. Oxidation of Hb sulfhydryl groups produces methemoglobin and intracellular precipitates of Hb known as Heinz bodies. Erythrocytes are particularly susceptible to oxidative stress as the hexose monophosphate shunt is their only source of NADPH.
Hundreds of mutations in the G6PD gene, located at Xq28, have been described, primarily missense mutations influencing enzyme kinetics, stability, or both. Because it is located on the X chromosome, G6PD deficiency primarily affects males, as they only carry 1 G6PD allele. Females can express 1 or 2 G6PD types and may be affected by G6PD deficiency depending on the degree of Lyonization of individual alleles. Only 1 X chromosome is active in any given cell, the Lyon hypothesis; thus, G6PD activity depends on the expression of wild type or mutant alleles. In women heterozygous for G6PD deficiency, average G6PD activity may be normal, mildly, moderately, or severely reduced, depending on the degree of Lyonization, making these G6PD-deficient erythrocytes susceptible to the same oxidant stress as G6PD-deficient cells in men. Typically, the overall degree of hemolysis in G6PD-deficient women is less because there is a smaller population of cells susceptible to oxidative stress.
G6PD deficiency is often classified into 3 clinical syndromes: 1) neonatal jaundice (NNJ), 2) CNSHA, and 3) acute hemolysis after exposure to an oxidative stressor. NNJ typically has an onset on the second or third day of life. While the degree is variable, severe cases resulting in kernicterus or even death have been described. In most cases, phototherapy is adequate therapy, with extreme cases requiring exchange transfusion. Anemia is uncommon in NNJ. In G6PD deficiency with CNSHA, there is chronic anemia, which may be exacerbated by oxidant exposure. Acute hemolysis after oxidant exposure, such as a sulfa drug, ascorbic acid, or fava beans, may occur at any age. Oxidant-induced hemolysis has occurred after maternal oxidant ingestion in utero in the G6PD-deficient fetus and in the breast-fed, G6PD-deficient infant.
Patients typically present with fever, nausea, abdominal pain, diarrhea, jaundice, and dark urine within 48 hours of oxidant exposure. The spleen and liver may be enlarged and tender. Laboratory findings include normochromic, normocytic anemia with anisocytosis, and reticulocytosis. Evidence of hemolysis may be seen. Heinz bodies, a classic finding in G6PD deficiency, may be seen. However, they are rapidly cleared from the circulation and may not be found. Additional laboratory findings include free Hb in the blood and hemoglobinuria. Semiquantitative screening tests are available, but these are unreliable after an acute hemolytic episode and do not typically detect female heterozygotes. Direct functional assays and DNA diagnosis can confirm the diagnosis.
Defects in enzymes of the Embden-Meyerhof glycolytic pathway, except for X-linked phosphoglycerate kinase, are inherited in an autosomal recessive manner. Pyruvate kinase deficiency (PKD), the most common abnormality of the Embden-Meyerhof pathway, is clinically heterogeneous, ranging from well-compensated anemia to transfusion dependence.14 Typical presentation is in infancy or early childhood with jaundice, pallor, and anemia. The need for phototherapy and transfusion is common in the neonatal period. Complications of PKD include gallstones and iron overload. Splenectomy improves anemia in many patients. Initial trials with oral, small molecule allosteric activators of pyruvate kinase show promise for patients with structural variants of pyruvate kinase.
Other rare defects of the Embden-Meyerhof pathway present in infants and children with jaundice and anemia.15 These include glucose phosphate isomerase deficiency, hexokinase deficiency, 2,3-biphosphoglycerate mutase deficiency, and phosphoglycerate kinase deficiency.16 Disorders of glutathione metabolism include γ-glutamyl cysteine synthetase and glutathione synthetase deficiency, which also present with anemia in infancy or childhood. Diagnosis of metabolic defects is confirmed by erythrocyte enzyme analyses or molecular testing.
Unstable Hbs
Unstable hemoglobinopathies, due to structural abnormalities of the α- or β-globin chain, are an underappreciated and underdiagnosed cause of dominantly inherited CNSHA.16 Unstable Hb leads to precipitates of heme and globin chain fragments forming Heinz bodies, the basis for the name congenital Heinz body hemolytic anemia. Unstable Hbs are detected by heat or isopropyl alcohol precipitation testing as not all unstable Hbs are associated with abnormally migrating bands on Hb electrophoresis. Molecular testing can verify the diagnosis. Treatment is supportive.
Two unstable Hbs present with hemolytic anemia in early infancy. Hb Hasharon is a mutant α-globin that, when paired with γ-globin, produces an unstable Hb. However, when mutant Hb Hasharon chains are paired with β-globin, it is no longer unstable, attributed to the 10-fold higher affinity between a and b chains than between a and g chains. Hb F Poole is an unstable Hb due to mutation in the g-globin chain. Hb Hasharon, Hb F Poole, and other unstable Hb variants influencing fetal Hb structure and function produce hemolytic anemia in early infancy resolve as the fetal-to-adult Hb switch occurs.
Hb Koln, the most common unstable Hb, is associated with compensated reticulocytosis, sometimes with erythrocytosis if the degree of hypoxia is greater than the degree of hemolysis. While inherited in an autosomal-dominant manner, de novo mutations are common.
SCD is considered with thalassemia syndromes.
Microangiopathic hemolysis
Thrombotic microangiopathy, clot formation in small blood vessels throughout the body, can lead to microangiopathic hemolytic anemia and thrombocytopenia. Disseminated intravascular coagulation, hemolytic uremic syndrome (HUS), and TTP are the most common causes of microangiopathic hemolysis in childhood.
Disseminated intravascular coagulation (DIC)
DIC is a common cause of anemia in critically ill infants and children. It is often associated with sepsis, meningitis, necrotizing enterocolitis, respiratory failure, pancreatitis, severe liver failure, as well as some malignancies and vascular malformations. In these diseases, DIC is suspected when there is bleeding and/or thrombosis in a patient with thrombocytopenia, hypofibrinogenemia, prolonged clotting times, and increased fibrin degradation products. Therapy for DIC is generally supportive, with the focus on the treatment of the underlying disease.
Kasabach-Merritt syndrome (KMS) is a rare, local consumptive coagulopathy that presents in the neonatal period with hypofibrinogenemia, thrombocytopenia, and microangiopathic anemia in association with an enlarging vascular malformation.17 The anemia and coagulopathy, which may be severe, improve with regression or removal of the tumor. Treatment of KMS focuses on the treatment of the vascular malformation and may include surgery, embolization, steroids, vincristine, or mTOR inhibitors.18 Hematologic abnormalities are treated supportively.
HUS
The triad of HUS is thrombotic microangiopathy with hemolytic anemia, thrombocytopenia, and renal involvement.19 HUS is a common cause of acute renal impairment in children, especially those <5 years old.20 Typical HUS is caused by Shiga-like toxin produced by Escherichia coli (O157:H7) or Shiga toxin produced by Shigella dysenteriae. Atypical HUS, defined as HUS without Shiga toxin, is associated with bacterial infection, medications, or immune-associated processes that lead to endothelial damage. Infections associated with atypical HUS include infections caused by Streptococcus pneumoniae, Clostridium difficile, Mycoplasma pneumoniae, HIV, histoplasmosis, influenza A virus, and coxsackievirus. Medications associated with atypical HUS include mitomycin C, cyclosporine, quinine, cisplatin, and cocaine. Patients with atypical familial HUS, a rare subtype due to inherited variants of the complement pathway that lead to endothelial damage, may suffer recurrent episodes of HUS.
Patients initially present with fever, abdominal pain, nausea, vomiting, and diarrhea which is often bloody.19 As the disease progresses, symptoms of anemia, jaundice, pallor, fatigue, renal impairment, hematuria, oliguria, or anuria develop. Laboratory findings include thrombocytopenia and anemia, as well as findings of hemolysis and renal dysfunction. Treatment includes supportive care and terminal complement blockade with eculizumab.21 A subset of patients develop oliguric renal failure requiring dialysis. Patients with atypical familial HUS may require plasma exchange. The long-term prognosis is good if there is prompt initiation of supportive therapy. Patients with severe colitis may develop intestinal strictures, while those with severe renal injury may develop chronic renal failure.
TTP
TTP is thrombotic microangiopathy characterized by thrombocytopenia, microangiopathic hemolytic anemia, fever, mucosal and skin bleeding, and ischemic changes in many organs, particularly the brain, kidney, and heart, accompanied by marked deficiency of functional ADAMTS13.22 TTP is primarily a disease of adults and is characterized by circulating antibodies to ADAMTS13. Much less commonly, the absence of functional ADAMTS13 is due to recessively inherited mutations in ADAMTS13, Upshaw-Schulman syndrome (USS).23
Approximately a third of pediatric TTP cases are associated with USS, with the remainder of pediatric cases being acquired. The first episode of TTP in USS typically occurs in infancy or early childhood with variable disease severity correlating with genotype and other unknown genetic or environmental influences. PB smear shows anisopoikilocytosis and marked schistocytosis. Treatment is with plasma exchange and, as indicated, steroids, rituximab, and other immune modulators. Caplacizumab shows good efficacy in adults and may ultimately replace plasma exchange.24,25
Paroxysmal nocturnal hemoglobinuria (PNH)
PNH, an acquired disorder of the cell membranes of multipotent marrow stem cells, is rare in children.26 Somatic mutation in a hematopoietic stem cell propagates into clonal populations of mutant blood cells susceptible to complement-mediated destruction, particularly clonal-derived erythrocytes, deficient in proteins that impede complement-mediated lysis via the constitutively-active alternative pathway.27 About two-thirds of pediatric patients have marrow failure, and the remainder have either intermittent or chronic anemia, often with leukopenia and thrombocytopenia. Hypoplastic or aplastic pancytopenia may precede or follow the diagnosis of PNH. Thrombosis and thromboembolism may occur. In rare cases, PNH may progress to acute myelogenous leukemia. Mortality is related to the development of aplastic anemia or thrombotic complications. Prior to eculizumab, the survival rate for children was 80% at 5 years, 60% at 10 years, and 28% at 20 years.
The severity of normocytic anemia is variable, and findings of chronic intravascular hemolysis are common. Poikilocytosis and anisocytosis are seen on PB smear. Hemoglobinuria is rarely seen in children compared with adults with PNH. Levels of erythrocyte acetylcholinesterase activity and decay-accelerating factor are decreased. Flow cytometry reveals low levels of CD59 on erythrocytes and low levels of CD55 and CD59 on granulocytes. Aerolysin testing of granulocytes and monocytes increases the sensitivity of detection by binding to glycosylphosphatidylinositol anchors. Treatment is with eculizumab, a monoclonal antibody against complement component C5 that interrupts the formation of the membrane attack complex, blocking downstream complement destruction of erythrocytes and activation of platelets. Because of the cost and lifelong duration of eculizumab treatment in children or cases of severe aplastic anemia, hematopoietic stem cell transplant (HSCT) is considered.
Oxidant exposure
Oxidant hemolysis is not always associated with an inherited metabolic abnormality of the erythrocyte, particularly in neonates. After a presumed exposure, there is acute-onset hemolytic anemia and hyperbilirubinemia with “bite” and “blister” cells and other irregularly shaped red cells on PB smear. Typically, no obvious source for the presumed oxidant stress is identified, and the episode resolves in a few days. Transfusion is rarely required.
Other causes of hemolysis
Other causes of hemolysis include snake bites, toxin exposure, galactosemia, prolonged or recurrent metabolic acidosis, lysosomal storage disease, and some amino acidopathies. In pregnancy, HELLP syndrome28 (hemolysis, elevated liver enzymes, and low platelet count) may occur, particularly in pregnancies complicated by preeclampsia or eclampsia. The primary treatment is delivering the baby as soon as possible.
Wilson disease
Wilson disease is a rare inherited disorder of copper metabolism due to mutation in ATP7B, a copper transporting ATPase, that leads to copper overload in the liver, brain, and other organs.29 Children have significant, progressive liver disease. Neurologic, psychiatric, renal, and joint manifestations may also be found. Hemolytic anemia may be severe and is sometimes the presenting sign.30 Neutropenia and thrombocytopenia may be observed. Treatment includes chelation, zinc supplementations, and liver transplantation in selected cases.
Immune hemolysis
Immune-mediated hemolysis in the pediatric age group includes neonatal alloimmune hemolytic disease, primary autoimmune hemolytic anemia, and secondary autoimmune hemolytic anemia. In some cases of immune-mediated anemia, antibodies are against antigens expressed on early erythroid progenitor cells, leading to an inappropriately low reticulocyte count clouding the diagnosis.31,32 Similarly, diagnosis of immune-mediated anemia in infants at their physiologic nadir with relative reticulocytopenia may be challenging.
Neonatal alloimmune hemolytic anemia
Neonatal alloimmune hemolytic anemia occurs when maternal antibodies produced against incompatible antigens present on fetal red blood cells cross the placenta and attack fetal erythrocytes.33 After birth, maternal antibodies continue to circulate and attack neonatal erythrocytes. This may lead to hemolysis with neonatal anemia and hyperbilirubinemia requiring treatment with phototherapy, erythrocyte transfusion, or exchange transfusion. While Rh-linked hemolysis has markedly decreased after the introduction of anti-D immunoglobulin prophylaxis, it remains a problem worldwide. ABO incompatibility, usually adequately treated by phototherapy alone, is now the most common cause of blood group incompatibility in Western countries. Alloimmunization to other erythrocyte antigens such as Kell, Fy, Jk, C, and E may also lead to neonatal alloimmune hemolytic anemia.
AIHA
AIHA, acquired hemolysis caused by the production of antibodies acting against the host’s own erythrocyte antigens, is uncommon in children, with a peak incidence <5 years of age.34 It is classified as primary AIHA (comprising 30% to 40% of pediatric cases in which no cause is found) or secondary AIHA (comprising 60% to 70% of cases where a triggering event is identified).
Demonstration of a positive DAT in a patient with hemolysis of unexplained cause is found in most cases of AIHA. The DAT detects immunoglobulins, typically IgG, or complement bound to the erythrocyte. However, a positive DAT is not specific, as it may be associated with several diseases such as malignancy, systemic lupus erythematosus, liver or kidney disease, or chronic infection, possibly via the passive deposition of immunoglobulins or immune complexes onto the erythrocyte. The indirect antiglobulin test detects erythrocyte antibodies in patient serum by incubating patient serum with a panel of known erythrocyte antigens and observing whether agglutination occurs.
Primary AIHA
Primary AIHA is immune-mediated hemolysis not associated with systemic illness, although in some cases, a history of a recent infectious disease is obtained.34 The role of infection as the initiating rather than causal factor in childhood AIHA is unknown.
Warm-reactive AIHA is the most common subtype of primary AIHA, associated with an IgG antibody that reacts at 37°C, rarely fixes complement, with extravascular hemolysis.35,36 In these patients, 3 patterns of reactivity may be noted on DAT: IgG alone, C3d alone, or both. The second form is paroxysmal cold hemoglobinuria. In this condition seen primarily in children, IgG-type antibodies bind and fix complement at 4°C and cause intravascular hemolysis. It is common after a viral-like infectious illness. The third form is cold agglutinin disease, which is more common in adults and is characterized by an IgM type antibody that binds red blood cells (RBCs) below 37°C, fixes complement, and leads to both extravascular and intravascular hemolysis. Standard DAT cannot detect IgM coating RBCs. Thus, DAT is typically positive only for complement. In children, it is usually seen after Mycoplasma infection.
In a few settings, patients with AIHA may have a negative DAT test when there is a low-affinity antibody, an immunoglobulin not tested for is present (eg, IgA), or there are low levels of erythrocyte-bound antibody.37 Additional testing, such as the indirect antiglobulin test or super Coombs testing, enhanced Coombs testing that utilizes different techniques to detect low-affinity antibodies, erythrocyte-bound antibodies below the limit of detection of the standard DAT, IgA antibody, erythrocyte-bound IgM, monomeric IgM antibody, and IgM warm antibody,38 is necessary to discern the diagnosis. Children with DAT‐negative AIHA often have a less severe clinical course and respond well to steroid therapy.
Primary AIHA is usually a self-limiting illness. Recurrence is uncommon. If anemia is severe, a course of steroids is prescribed,39 sometimes with IVIG. Second-line therapy, including anti-CD20 monoclonal antibody therapy with rituximab, immunomodulatory drugs such as danazol, azathioprine, cyclosporine, high-dose cyclophosphamide, and vincristine, may be required if there is no response to steroids or there is steroid dependence. Third-line therapy considers splenectomy. Overall mortality is a few percent.
Secondary AIHA
Secondary AIHA is immune-mediated hemolysis associated with systemic illness. These include infection with a variety of organisms such as Epstein-Barr virus, cytomegalovirus (CMV), Mycoplasma, pneumococcus, and parvovirus, malignancy such as Hodgkin lymphoma, autoimmune diseases such as systemic lupus erythematosus, rheumatoid arthritis, ulcerative colitis, Evans syndrome, and autoimmune lymphoproliferative syndrome, liver disease (particularly giant cell hepatitis) after solid organ or hematopoietic cell transplantation,40,41 and inherited and acquired immunodeficiency syndromes such as common variable immunodeficiency. This is the basis for the recommendation to examine serum immunoglobulins, antinuclear antibodies, and lymphocyte subsets in children presenting with AIHA.40
Another type of secondary AIHA is drug-associated immune hemolytic anemia.42 Suspicion for this diagnosis is when there is acute onset of hemolysis after initiation of a potentially offending drug. Cases have been described after administration of ceftriaxone, piperacillin, fludarabine, cefotetan, and diclofenac have been implicated. Specialized laboratory testing may aid in the diagnosis.
Many children with secondary AIHA present with signs of acute hemolysis with abrupt onset of pallor, jaundice, fatigue, and dark urine. If anemia is severe, there may be signs of cardiovascular compromise, acute renal insufficiency, and neurologic findings. Important in the investigation of secondary AIHA is the consideration that hemolysis may be one of the initial manifestations of a serious systemic disease. Treatment includes treating the associated systemic illness with specific therapy similar to that of primary AIHA, including steroids, IVIG, and rituximab.
Normocytic anemia with normal or decreased reticulocyte count
This category of anemias is associated with acute blood loss due to hemorrhage, early stages of acute hemolysis, chronic disease, acute inflammatory states, and malignancies.
Acute hemorrhage
Acute trauma due to motor vehicle accidents, falls, and assaults are 3 of the most common causes of trauma in pediatric patients associated with acute hemorrhage. In some cases, a high index of suspicion is needed when blood loss may be occult (eg, from a ruptured spleen or lacerated liver) due to an event not initially reported, such as a sports collision or a bicycle fall.43 Outside of trauma, in older children, the GI tract is a common site of blood loss associated with a variety of disorders, including Meckel’s diverticulum, ulcerative colitis, Crohn’s disease, single or multiple polyps, esophageal and gastric varices, and in menstruating girls, blood loss due to dysmenorrhea. Dysmenorrhea may be associated with von Willebrand disease and other bleeding disorders, so it is important to inquire about frequent nose bleeds, easy bruising, and family history of the same. In neonates, acute blood loss may have occurred due to fetomaternal or fetoplacental hemorrhage, abruptio placentae, or placenta previa.
Acute hemolysis
Patients with acute onset hemolysis may present with marked normocytic anemia before there has been a reticulocyte response. This may be the presentation of AIHA after viral or Mycoplasma infection. Acute hemolysis may occur after an acute oxidant challenge in patients with G6PD deficiency, an unstable Hb, or metabolic defects. It may occur with acute splenic sequestration in SCD and other disorders. S. pneumoniae infection may produce an enzyme that exposes the Thomsen-Friedenreich cryptoantigen (or T antigen) found on erythrocytes, platelets, and glomeruli. Antibodies to the T antigen, which are normally found in human serum, bind the exposed T antigen, and the antigen-antibody reaction leads to atypical HUS and hemolytic anemia.44 A similar situation may occur in neonates with necrotizing enterocolitis and Clostridium welchii or C. perfringens infection.45 One of the toxins produced by clostridial organisms cleaves sialic acids from erythrocyte membrane glycoproteins exposing the T antigen. Transfusion of adult blood, which almost always contains anti-T antibodies, may lead to severe, rapidly progressive intravascular hemolysis causing acute renal failure, hypovolemic shock, and death. In hospitalized patients, hemolysis may occur after transfusion reaction from major blood group incompatibility.
Chronic disease/inflammation
Anemia of chronic disease/inflammation is found in patients with a wide variety of disorders, infection, malignancies, renal disease, rheumatologic disorders, heart failure, chronic lung disease, and GI diseases such as ulcerative colitis, Crohn’s disease, and celiac disease. Several factors contribute to anemia. These include mild hemolysis, decreased sensitivity of erythroid precursors to erythropoietin due to inflammatory cell-produced cytokines, and inflammation-mediated increased synthesis of hepcidin, which binds ferroportin, blocks iron export from the liver and GI tract, and decreases iron levels available to developing erythroid cells.46 Many of these patients also have iron deficiency and chronic inflammation, exacerbating the anemia.
Anemia of chronic disease/inflammation is typically normocytic but may be microcytic if iron deficiency is prominent. Erythropoietin levels are low commensurate to the degree of anemia. Hepcidin levels, erythrocyte sedimentation rate, and C-reactive protein levels are often elevated. Treatment of the underlying condition improves the anemia. In some patients, erythropoietin-stimulating agents are prescribed. Severe cases require transfusion.
Transient erythroblastopenia of childhood (TEC)
TEC is a rare red cell aplasia of young children or infants, usually occurring after a viral infection.47 Normocytic normochromic anemia and reticulocytopenia are sometimes accompanied by neutropenia and thrombocytosis. Marrow examination is normal. After 1 to 2 months, patients undergo spontaneous recovery.
Microcytic anemia
Microcytic anemia with normal or decreased reticulocyte count
Iron deficiency anemia
Iron deficiency and iron deficiency anemia are common throughout the world.48 Among children in developing countries, iron deficiency is the most common nutritional deficiency, whereas in industrialized countries, while the incidence is decreasing, attributed in part to iron fortification of infant formulas and cereals, it remains a common cause of anemia in children and adolescents. The link of iron deficiency, even without anemia and more important than anemia, is the relationship between iron deficiency and cognitive defects,49 some of which may be reversible.
The American Academy of Pediatrics recommends universal screening for anemia in all children around 1 year of age, including assessing for risk factors such as history of prematurity, low birth weight, lead exposure, exclusive breastfeeding without iron supplementation beyond 4 months, as well as feeding problems, poor growth, low socioeconomic status, Mexican American descent, and special health care needs.50 Iron deficiency occurring in older children and adolescents may be associated with poor diet, malabsorption syndromes, and chronic blood loss, particularly in menstruating girls and women. In developing countries, infection with hookworm and schistosomiasis are important causes of iron deficiency.
Iron deficiency is often symptomatic and may or may not be accompanied by anemia. Signs of iron deficiency in infants include poor feeding and irritability.51 In older children and adolescents, iron deficiency may be associated with lethargy, fatigue, pallor, difficulty concentrating, headache, and tinnitus. Other signs may include atrophic glossitis, alopecia, dry hair, dry skin, and koilonychia. Some iron-deficient patients exhibit pica, the compulsive ingestion of nonnutritive substances, sometimes attributed to lack of iron in some areas of the brain.52 Iron deficiency has been associated with poorer functional outcomes such as impaired neurocognitive development, exercise performance, and pregnancy outcome.53
Laboratory testing reveals decreased Hb levels, decreased mean corpuscular volume, and decreased mean corpuscular Hb level. PB smear shows significant anisocytosis, hypochromia, and microcytosis (Figure 4). A variety of tests have been employed in the assessment of iron deficiency anemia (Figure 5).53 Decreased serum ferritin <10-12 mg/L in conjunction with a normal C-reactive protein, decreased reticulocyte Hb concentration (CHr), decreased serum iron levels, and decreased transferrin saturation are indicative of iron deficiency. CHr, a good indicator of iron availability and iron-deficient erythropoiesis, is a popular test as it is easily obtained from most automated blood cell analyzers. The RDW is elevated in iron deficiency. In otherwise well children, a trial of iron supplementation without additional laboratory testing is a strategy frequently used to diagnose iron deficiency.
Markers of iron deficiency. *Diagnostic thresholds for reticulocyte Hb content vary between the type of blood cell analyzer as well as for hepcidin and soluble transferrin receptor assays. Reprinted with permission from Pasricha et al.120
Markers of iron deficiency. *Diagnostic thresholds for reticulocyte Hb content vary between the type of blood cell analyzer as well as for hepcidin and soluble transferrin receptor assays. Reprinted with permission from Pasricha et al.120
Treatment is with an iron-rich diet and oral iron supplementation. Infants <1 year of age should be provided breast milk or iron-fortified formula, and cow’s milk avoided. In addition, after 6 months of age, foods rich in iron, such as iron-fortified cereal and pureed meats, can be given. After a year of age, cow’s milk intake should be limited. Supplementation is initiated with 3 mg/kg ferrous sulfate given once a day in the morning or between meals without milk or other dairy products, which may inhibit absorption.54 In adolescents, treatment includes appropriate nutritional intake, as poor dietary habits often contribute to iron deficiency, and 60 mg elemental iron twice a day.55 After initiating therapy, follow-up laboratory testing should be performed in 2 to 4 weeks, assessing reticulocyte and Hb response.
In cases of iron deficiency unresponsive to oral therapy, poor compliance to therapy, persistent low-iron diet, ongoing malabsorption or blood loss, and an incorrect diagnosis should be considered. Conditions in the differential diagnosis include cow’s milk protein-induced colitis, celiac disease, inflammatory bowel disease, malaria, hookworm, schistosomiasis, as well as thalassemia trait or presence of the anemia of chronic inflammation. In the anemia of chronic inflammation, systemic immune activation leads to alterations in iron metabolism leading to iron retention in macrophages and reduced iron absorption, with iron deficiency one of the contributors to anemia.56 In refractory cases, the diagnosis of iron-refractory iron deficiency anemia (IRIDA), a recessively inherited disorder due to mutations in TMPRS6, should be considered.57 In both anemia of chronic inflammation and IRIDA, dysregulation of hepcidin,53 the primary regulator of systemic iron homeostasis, lead to iron-restricted or iron-deficient erythropoiesis with poor response to oral iron therapy.58
In some cases, parental iron supplementation may be indicated. Patients with poor compliance or oral iron tolerance, malabsorption due to various GI disorders, ongoing, controlled blood loss, and patients with anemia of chronic inflammation or IRIDA are candidates for parenteral iron.
Lead intoxication
Ingestion of lead-contaminated dust and paint chips from interior surfaces of older homes with deteriorating lead-based paint and exposure to soil contaminated by leaded gasoline and lead-based paints are the most common causes of lead poisoning in the United States. Other sources of lead include contaminated drinking water, imported food in soldered cans, imported chocolate and candy, and ceramic pottery. There is no lead poisoning-specific signs or symptoms, only nonspecific findings such as abdominal pain, constipation, nausea, vomiting, decreased growth, delayed sexual maturation, increased dental caries, and impaired neurologic development. A high index of suspicion is required. Associated anemia is hemolytic as lead poisoning is accompanied by an acquired deficiency of erythrocyte pyrimidine 5′-nucleotidase.
The Centers for Disease Control and Prevention (CDC) and the American Academy of Pediatrics both recommend targeted screening of all Medicaid-enrolled and -eligible children, as well as those who were born outside of the United States.59 Studies have shown an association between low iron levels and elevated blood lead levels in infants and children, supporting theories that iron deficiency increases a child's susceptibility to lead poisoning and sufficient iron stores reduce the risk of lead poisoning. Treatment includes removal of the child from the offending environment or removal of the cause of the exposure. In more severe cases, chelation is required. With these measures, anemia resolves. The CDC recommends all lead-intoxicated children be tested for concomitant iron deficiency. The association between iron deficiency, pica, and lead intoxication has been known for centuries.
Hb disorders
Microcytosis with mild to no anemia and minimal reticulocytosis may be due to α- or β-thalassemia trait or heterozygous γδβ-thalassemia. Determining the etiology of microcytic anemia includes assessment of iron stores and Hb electrophoresis (Figure 5). The RDW is elevated in over half the cases of iron deficiency anemia but normal in the thalassemia trait. A Mentzer index (MCV/RBC) of <13 suggests thalassemia trait, whereas >13 suggests iron deficiency.60
Sideroblastic anemias
The congenital sideroblastic anemias (CSAs) are rare disorders of mitochondrial dysfunction due to defects in heme biosynthesis, iron-sulfur cluster biogenesis, generalized mitochondrial protein synthesis, or abnormalities in specific mitochondrial respiratory chain proteins involved in oxidative phosphorylation.61 CSAs are classified into syndromic and nonsyndromic forms.
Syndromic CSAs include TRNT1 mutations manifest by sideroblastic anemia, B-cell immunodeficiency, periodic fevers, and developmental delay, mutations in PUS1, YARS2, LARS2 manifest by myopathy, lactic acidosis, sideroblastic anemia, and ABCB7 mutations associated with ataxia. Nonsyndromic CSA presents with isolated anemia without other clinical manifestations and includes X-linked sideroblastic anemia (XLSA) due to heterozygous mutations in ALAS2, which encodes the erythroid-specific form of the heme biosynthetic enzyme 5-aminolevulinate synthase,62 or less commonly, mutations in SLC25A38, HSPA9, HSCB, NDUFB11, GLRX5, and FECH.63
XLSA is the most common nonsyndromic CSA.62 Patients present with microcytic anemia, which may be severe, requiring transfusion support. Laboratory findings include microcytic anemia, elevated RDW, PB smear with microcytosis, marked hypochromia, anisocytosis, poikilocytosis, target cells, and occasional siderocytes (Figure 4). Bone marrow (BM) aspirate shows abundant ring sideroblasts. Anemia is normocytic or macrocytic in females as skewed X-chromosome inactivation in hematopoietic stem and progenitor cells leads to predominantly nonviable erythroid precursors carrying a mutant ALAS2 allele that undergo intramedullary hemolysis while circulating erythrocytes represent the progeny of erythroid precursors carrying the normal ALAS2 allele. Erythropoietin drives increase production of these normal erythrocytes with rapid release from the marrow leading to macrocytosis.
Treatment of syndromic CSA is primarily related to the nonhematologic features of the disease and their management. Treatment of nonsyndromic CSA revolves around the treatment of anemia and prevention of iron overload.61 Vitamin B6, an essential cofactor for the ALAS enzyme, supplements are prescribed in cases of XLAS.
Microcytic anemia with increased reticulocyte count
Disorders of Hb
Disorders of Hb, including thalassemia syndromes and SCD, are among the most common monogenic disorders worldwide.64 The thalassemias are disorders characterized by a decreased or absent globin chain production due to numerous point mutations or deletions in either the α- or β-globin genes. Globin chain deficiency leads to ineffective erythropoiesis as excessive unpaired globin chains produce insoluble tetramers leading to oxidant damage of erythrocyte membrane lipids and proteins.
Similar to G6PD deficiency, thalassemic-deficient erythrocytes demonstrate a selective advantage against P. falciparum infection, leading to a high frequency of Hb disorders worldwide via natural selection. Other contributors to the high frequency of thalassemia in southern Asia, the Middle East, the Mediterranean, and North and Central Africa are gene drift and founder effects. Mass migration out of areas of high prevalence has led to the finding of thalassemia in most countries worldwide, including the United States, Canada, northern Europe, Australia, and South America.65
Differences in the clinical manifestations of the thalassemia syndromes are due to developmental differences in globin chain synthesis. The primary embryonic α-like globin, ζ-globin, is produced in the yolk sac as early as 3 weeks gestation. By 9 weeks of gestation, α-globin is the primary fetal α-like globin, with only small amounts of the embryonic ζ-globin found. Α-globin continues to be the primary α-like chain throughout infancy and into adulthood. In contrast, the switch from fetal to adult β-like globin chains, γ- to β-globin, is not complete until 6 to 12 months after birth. The primary embryonic β-like globin is ε-globin, whose production roughly parallels that of ζ-globin. Beginning at 3 to 4 weeks gestation, γ-globin production begins, replacing ε-globin by 9 weeks gestation. α and γ chains pair to produce fetal Hb (HbF) (α2γ2). Β-globin production begins increasing in the third trimester and eventually replaces HbF with adult Hb (HbA) (α2β2) by 6 to 12 months after birth. Thus, abnormalities of α-globin, such as homozygous α-thalassemia, lead to severe anemia in utero, whereas abnormalities of β-globin, such as homozygous β-thalassemia and SCD, do not typically manifest in the first few months of life while HbF levels are still high.
α-Globin defects
The clinical picture in the α-thalassemia syndromes is related to the numbers of functional α-globin genes present.66 Deletion of 1 α-globin gene leads to an asymptomatic carrier state. Deletion of 2 α-globin genes leads to α-thalassemia trait with mild hypochromic, microcytic anemia. Deletion of 3 α-globin genes leads to Hb H disease with variable anemia, from mild to very severe. Deletion of all α-globin genes leads to homozygous α-thalassemia. In some cases, α-globin defects are due to nondeletional variants such as nonsense and nonsense mutations. Overall, the clinical manifestations of nondeletional α-thalassemia are variable. The most common of these, Hb Constant Spring, common in Southeast Asia and the Mediterranean, is associated with a more severe phenotype than deletional types of α-thalassemia.67
Homozygous α-thalassemia
In homozygous α-thalassemia, the primary Hb present is a tetramer of unpaired non-α chains, γ4, known as Hb Barts. Most cases lead to the death of the affected fetus in utero from severe hemolytic anemia, congestive heart failure, and nonimmune hydrops fetalis.66 Mothers of affected fetuses are at risk of numerous complications, including pregnancy-induced hypertension, antepartum hemorrhage, difficult delivery, retained placenta, and post-partum hemorrhage.68,69 Survival of the homozygous fetus to late gestation depends on the presence and amount of embryonic Hb Portland, ζ2γ2. In the few cases where an infant with homozygous α-thalassemia is born alive without prior intervention, death from cardiopulmonary collapse usually occurs shortly after birth. Genetic screening of at-risk populations has allowed the identification of couples at risk for conceiving an affected fetus. In a few cases, in utero and postnatal transfusion therapy with iron chelation have led to survival. HSCT is an option for affected patients. Long-term complications include growth failure and neurodevelopmental disability in ∼20%.69
Hb H disease
Patients with Hb H disease present in the neonatal period with hypochromic, microcytic hemolytic anemia and hyperbilirubinemia.70 A few patients suffer from nonimmune hydrops fetalis in utero, with microcytosis and red cell fragmentation. Hb electrophoresis is diagnostic, demonstrating Hb Barts and Hb H, β4.
β-Globin defects
γδβ- and εγδβ-thalassemia
Large deletions of the β-globin gene cluster lead to the phenotype of γδβ- and εγδβ-thalassemia.71,72 Patients present with significant hypochromic hemolytic anemia with prominent normoblastosis in the neonatal period. Over time, the anemia improves, and erythrocyte morphology evolves to that similar to the β-thalassemia trait. An interesting feature of γδβ-thalassemia is the finding of normal HbA2 levels, often leading to misdiagnosis as iron deficiency.
β-Thalassemia
Numerous β-globin gene mutations, usually point mutations or small deletions, lead to disease of variable severity.73 Inheritance of a single heterozygous mutation leads to the phenotype of β-thalassemia trait or minor, characterized by mild microcytic anemia. β-Thalassemia trait is often discovered when a child with microcytic anemia does not respond to an empiric trial of iron supplementation. Inheritance of 2 β-globin mutations, one associated with a mild phenotype, leads to β-thalassemia intermedia, characterized by clinical severity between β-thalassemia trait and β-thalassemia major. Thalassemia intermedia patients have symptoms ranging from mild anemia with little need for transfusion to chronic hemolytic anemia developing transfusion dependence later in life.74 Patients develop iron overload, splenomegaly, leg ulcers, thrombophilia, and bony abnormalities. Treatment, outlined in a series of guidelines,75 may include transfusion, iron chelation, even splenectomy, despite increased risk for thrombosis after splenectomy,76 and HSCT, is tailored to patient disease severity.
Inheritance of 2 severe β-globin gene mutations in a compound heterozygous or homozygous manner leads to β-thalassemia major. Symptoms of anemia, including poor growth, irritability, and lethargy, develop during the second 6 months after birth as fetal Hb levels decline; thus, severe microcytic anemia in an older infant with these findings should prompt investigation for β-thalassemia major. If untreated, ineffective erythropoiesis may lead to hepatosplenomegaly, frontal bossing, and paravertebral pseudotumors. There is microcytic, hypochromic hemolytic anemia with poikilocytosis, target cells, teardrop cells, and fragments on PB smear (Figure 4). Hb electrophoresis is diagnostic. Treatment includes chronic transfusions, chelation, erythroid maturation agents such as luspatercept, and consideration for HSCT. Recent advances in gene therapy may provide alternative therapeutic options.77
HbE
The HbE allele is due to a splicing mutation of the β-globin gene that is transcribed at reduced levels and translated into an abnormal β-globin protein. Reduced expression of this abnormal β-globin leads to clinical findings similar to the β-thalassemia trait. HbE is common in individuals from the Indian subcontinent and Southeast Asia. Because β-thalassemia variants are also common in these regions, the coinheritance of β-thalassemia and HbE alleles occurs frequently.78 Clinical findings are heterogeneous, ranging from mild to moderate microcytic anemia to severe transfusion-dependent anemia. The diagnosis should be suspected when a child of Asian ancestry presents with microcytic anemia of unknown cause with normal iron indices. Diagnosis is by Hb electrophoresis. Treatment is based on disease severity. Chelation may be required when iron overload occurs.
SCD
SCD is the most common inherited blood disorder in the United States, affecting ∼100 000 people,79 impacting 1 out of 365 African American births and 1 out of 1630 Hispanic American births. It affects millions of people worldwide, especially peoples in or whose ancestors originated from sub-Saharan Africa, South America, the Caribbean, Central America, Saudi Arabia, India, Turkey, Greece, and Italy. The most common and most severe type is homozygous SS disease, followed by SCD and sickle-β–thalassemia. The sickle mutation, Glu6Val, leads to the expression of sickle Hb, which is susceptible to polymerization under deoxygenated conditions changing erythrocyte deformability.80 This leads to hemolysis of poorly deformable sickle erythrocytes, blood vessel vaso-occlusion, and an array of other pathophysiologic findings.
Clinical complications include painful vaso-occlusive episodes, splenic dysfunction, and multiorgan disease, including the risk of stroke.80 Diagnosis in most cases is made by newborn screening Hb electrophoresis. Clinicians should suspect SCD in immigrant children from countries without newborn screening programs presenting with complications of the disease, such as hemolytic anemia, sepsis, or dactylitis.81 Treatment is tailored to the patient and may include transfusion therapy, induction of HbF with hydroxyurea, upregulation of antioxidant and reactive oxygen species scavenging processes by l-glutamine, antiadhesion therapy with an anti-P–selectin antibody crizanlizumab, and stabilizing sickle Hb to its high-oxygen affinity R-state via allosteric modification with voxelotor.82 HSCT, especially if a sibling-matched donor is available, is a consideration. New gene therapy approaches may provide additional therapeutic approaches.
HbC
The HbC allele, Glu6Lys, is a common structural variant of β-globin associated with mild disease. Patients with the HbC trait, HbAC, are phenotypically normal, while patients with homozygous HbC, HbCC, exhibit very mild hemolysis. When HbC is inherited in trans to Hb S (HbS), it produces an SCD phenotype.83 Sickle cell (SC) erythrocytes demonstrate dehydration, increased viscosity, and intracellular sickling. HbSC patients demonstrate many of the same findings as Hb SS patients but in lesser forms. Some prominent phenotypic features of HbSC disease include retinitis, osteonecrosis, and acute chest syndrome.
Macrocytic anemia
Macrocytic anemia with normal or decreased reticulocyte count
Erythrocyte underproduction is an uncommon cause of anemia in pediatric patients. Associated abnormalities include nutritional deficiencies, genetic syndromes, congenital dyserythropoietic anemias, BM replacement syndromes, drug-induced anemia, infectious suppression, and other rare causes. Depending on the time in the disease course and any associated diagnoses, anemia may be normocytic, microcytic, or macrocytic, particularly for nutritional and infectious etiologies of anemia.
Nutritional anemias
Vitamin B12 deficiency
Vitamin B12 deficiency in pediatric patients is found when there is a decreased intake, reduced absorption, or inherited abnormalities of vitamin B12 absorption, transport, or metabolism.84 Decreased intake is associated with a strict vegetarian diet or breastfeeding by a vitamin B12-deficient mother. Decreased absorption is associated with decreased stomach acid, gastrectomy, bowel resection, poor pancreatic function, parasitic infection, bacterial overgrowth, Crohn’s disease, or celiac disease. Inherited disorders include abnormalities of intrinsic factor, transcobalamin-II deficiency, cobalamin R-binder protein deficiency, defects in vitamin B12 intestinal absorption known as Imerslund-Gräsbeck syndrome, and several very rare metabolic disorders. Antibody-mediated vitamin B12-deficient pernicious anemia, common in adults, is rare in childhood.
Vitamin B12 deficiency typically presents with poor growth, developmental delay, and neurologic abnormalities such as weakness or irritability.84 Macrocytic anemia, and sometimes pancytopenia, is observed with anisocytosis, basophilic stippling, and hyper segmented neutrophils on PB smear. In a few cases, infants have presented with transfusion-dependent anemia. Treatment of symptomatic B12 deficiency is with vitamin B12, along with dietary or medication adjustments as indicated.
Folate deficiency
Folate deficiency in pediatric patients is found when there is a decreased intake, reduced absorption, impaired utilization, or increased requirements. Decreased intake is seen in infancy when there is feeding of a folate-poor diet such as goat’s milk or milk that has been boiled. In older children, decreased intake is associated with poor dietary habits, although dietary-associated folate deficiency has decreased since 1998 when the US Food and Drug Administration required manufacturers to add folic acid to enriched flour, bread, cereal, pasta, rice, and other grain products to decrease the risk of neural tube defects. Impaired folate absorption is seen in patients with celiac disease, congenital malabsorption syndromes, after intestinal resection, and those receiving certain medications such as sulfasalazine. Impaired utilization of folate is seen in patients receiving folic acid antagonists such as methotrexate, sulfa antibiotics, and several antiepileptics. Increased folate requirements are seen during pregnancy, in preterm infants, and in patients with hyperthyroidism, malignancies, and chronic hemolytic disease.
The megaloblastic anemia of folate deficiency in infants and children is like that observed in adults. Treatment depends on treatment of the underlying cause and supplementation.85 Folate deficiency due to dietary deficiency or increased demands is best treated with folate supplements along with a folate-rich diet. Deficiency due to folic acid antagonists such as sulfa drugs is treated with folate supplementation or by reducing or eliminating the offending drug.
Genetic syndromes
Diamond-Blackfan anemia (DBA)
DBA is a disorder characterized by congenital erythroid cell aplasia typically diagnosed in the first year of life.85 About half of cases are sporadic, and half are dominantly inherited, with rare cases exhibiting X-linked inheritance. Nonhematologic abnormalities may first bring patients to medical attention. These include small for gestational age, abnormalities of the thumb or radius, microcephaly, hypertelorism, flat nose, low set ears, cleft or high arched palate, retrognathia, and less commonly, genitourinary, cardiac, or bony defects. Laboratory findings include macrocytic anemia, low reticulocyte count, elevated erythrocyte adenosine deaminase in 80% to 85% of cases, and elevated HbF. BM examination shows normal cellularity with a paucity of erythrocyte precursors, or in severe cases, marked myeloid predominance (Figure 7). Genetic testing may be performed.
BM examination. (A) Diamond-Blackfan anemia. BM aspirate shows a marked myeloid predominance. (B) Acquired aplastic anemia. High-power image of a hematoxylin and eosin-stained BM biopsy section from a teenage girl showing profound hypocellularity. The few remaining hematopoietic cells are lymphocytes, plasma cells, and macrophages with pigment in their cytoplasm. (C) Congenital dyserythropoietic anemia (CDA) type II. BM aspirate shows binucleated and multinucleated erythroid precursors. (D) Neuroblastoma. BM biopsy shows clumps of metastatic neuroblastoma cells. These images were originally published in the ASH Image Bank. (A) Amy Duffield, Diamond Blackfan Anemia Aspirate, 2015, #00060078. (B) Kristian T. Schafernak, Acquired Aplastic Anemia, 2016, #00060876. (C) Kristian T. Schafernak, Congenital Dyserythropoietic Anemia, Type II, 2016, #00060891. (D) Suzanne Vercauteren. Neuroblastoma Bone Marrow, 2015, #00060131. © The American Society of Hematology.
BM examination. (A) Diamond-Blackfan anemia. BM aspirate shows a marked myeloid predominance. (B) Acquired aplastic anemia. High-power image of a hematoxylin and eosin-stained BM biopsy section from a teenage girl showing profound hypocellularity. The few remaining hematopoietic cells are lymphocytes, plasma cells, and macrophages with pigment in their cytoplasm. (C) Congenital dyserythropoietic anemia (CDA) type II. BM aspirate shows binucleated and multinucleated erythroid precursors. (D) Neuroblastoma. BM biopsy shows clumps of metastatic neuroblastoma cells. These images were originally published in the ASH Image Bank. (A) Amy Duffield, Diamond Blackfan Anemia Aspirate, 2015, #00060078. (B) Kristian T. Schafernak, Acquired Aplastic Anemia, 2016, #00060876. (C) Kristian T. Schafernak, Congenital Dyserythropoietic Anemia, Type II, 2016, #00060891. (D) Suzanne Vercauteren. Neuroblastoma Bone Marrow, 2015, #00060131. © The American Society of Hematology.
DBA is caused by a number of mutations, many in ribosomal protein genes, including RPS19 (most common), RPL5, RPS10, RPL11, RPL35A, RPS7, RPS17, RPS24, RPS26, RPL19, RPL26, RPS29, RPL31, RPS28, RPS20, RPL15, RPL17, TSR2, and GATA1 genes.86 Treatment includes transfusions, steroids, or HSCT.87 DBA patients have an increased risk of myelodysplastic syndrome, certain cancers, adrenal insufficiency, hypogonadism, or hypothyroidism later in life.
Aase syndrome
Aase syndrome is a very rare, congenital hypoplastic anemia with triphalangeal thumbs.88 Poor growth and other bony abnormalities, including a hypoplastic radius, may be seen. In affected families, autosomal recessive inheritance has been suggested. Due to overlapping features, some have suggested Aase syndrome is a variant of DBA.
Fanconi anemia (FA)
FA is a BM failure syndrome due to defects in the FA pathway, a biochemical network important for DNA repair, DNA replication, and other cellular processes. FA is due to recessively inherited mutations in 1 of at least 22 genes, with most cases due to mutations in 1 of 3 genes, FANCA, FANCC, and FANCG, important components of the FA pathway core complex.89 Similar to DBA, nonhematologic abnormalities may first bring patients to medical attention. These include small for gestational age, abnormalities of the thumb or radius, patches of abnormal skin pigmentation, genitourinary, cranial, or heart defects, abnormalities of the eye, and hearing loss. FA patients diagnosed in infancy appear to have a higher incidence of multisystem involvement than those diagnosed later in life. Progressive hematologic dysfunction and marrow failure develop during childhood.
Pancytopenia leads to symptoms of frequent infection, excessive bleeding, and anemia. As adults, many FA patients experience infertility. They are at risk of developing solid tumors and other cancers and are particularly prone to the development of myelodysplastic syndrome and acute myelogenous leukemia.90
FA is diagnosed based on symptoms, clinical findings and course, and laboratory testing. Blood counts may reveal neutropenia, thrombocytopenia, and macrocytic anemia with reticulocytopenia. HbF levels are sometimes elevated. BM examination is variable, ranging from normal cellularity to total aplasia, sometimes with dysplastic features. Clonal cytogenetic abnormalities may be identified in marrow samples of older patients. The chromosome breakage test demonstrates marked chromosome breakage in lymphocytes or fibroblasts cultured with a DNA crosslinking agent such as mitomycin C or diepoxybutane due to the underlying defect in DNA repair. Genetic testing may be confirmatory. Treatment is variable and is based on disease severity. In some cases, growth factors or androgens may be administered. HSCT is the only curative therapy.
Shwachman-Diamond syndrome (SDS)
SDS is a rare disorder presenting in infancy with exocrine pancreatic insufficiency, poor growth, skeletal abnormalities, and BM failure. Neutropenia is often the first hematologic abnormality, progressing to include anemia or pancytopenia.91 Patients also may experience poor growth, developmental and intellectual delays, and frequent infections. Laboratory findings show varying degrees of cytopenias. BM cellularity is variable, ranging from high to low, with elements of dysplasia. Cytogenetic abnormalities of chromosome 7 may be found. With advancing age, SDS patients are at risk for the development of myelodysplastic syndrome or acute myeloid leukemia.92
Diagnosis is made based on symptoms, clinical findings and course, and genetic testing. Most cases are due to recessively inherited mutations in the SBDS (most common), DNAJC21, or EFL1 genes,91 or rarely with dominant or de novo mutations in SRP54. Treatment is based on associated findings such as the replacement of missing pancreatic enzymes and a special diet with fat-soluble vitamins. Patients with severe anemia may require blood transfusions. HSCT is an option in severe cases.
Dyskeratosis congenita (DC)
DC is characterized classically by the triad of oral leukoplakia, nail dystrophy, and lacy skin pigmentation. However, clinical severity is variable, and this triad is not required for diagnosis. Skin and nail findings often present early in childhood, followed by BM failure, which occurs by 20 years in over two-thirds of patients. Anemia in childhood is uncommon.93 Other complications include the development of pulmonary fibrosis, myelodysplastic syndrome, leukemia, and other cancers. DC is caused by mutations in genes encoding proteins influencing telomere length, leading to abnormal telomere shortening.94 Diagnosis is made by clinical signs and symptoms, analysis of telomere length in PB granulocytes and lymphocytes, and genetic testing. Treatment focuses on strategies to preserve the skin, liver, and lungs. HSCT and solid organ transplantation have been employed.95
Pearson syndrome
Pearson syndrome is a rare mitochondrial DNA deletion disorder associated with macrocytic anemia, metabolic acidosis, and exocrine pancreatic insufficiency attributed to a lack of enzymes involved in oxidative phosphorylation.96 Some patients lack metabolic abnormalities and exhibit only sideroblastic anemia. Neutropenia and thrombocytopenia, typically mild, may also be present.
Other disorders
Other disorders that may present with pancytopenia include congenital amegakaryocytic thrombocytopenia and hemophagocytic lymphohistiocytosis.
Aplastic anemia
Idiopathic acquired aplastic anemia is a rare, life-threatening BM failure syndrome characterized by severe persistent pancytopenia and hypocellular BM (Figure 7) in the absence of major dysplastic signs or marrow fibrosis.97 It is more common in older children and adolescents. Known associations include infection, particularly viral infection, malignancies, autoimmune disease, medications, toxins, and after radiation or chemotherapy. The pathophysiology is unknown. One model suggests a dysregulated immune system leads to autoreactive T-cell destruction of hematopoietic stem and progenitor cells in a genetically susceptible host. When considering the diagnosis, inherited BM failure syndromes should be excluded. Patients with acquired aplastic anemia are typically treated with immunosuppressive therapy or HSCT.98,99
Congenital dyserythropoietic anemia (CDA)
CDA syndromes are a group of disorders characterized by anemia with ineffective erythropoiesis and reticulocytopenia relative to the degree of anemia.100 The CDAs are heterogeneous in their clinical and laboratory manifestations as well as their genetic etiologies.
Type I CDA is characterized by mild to moderate macrocytic anemia with relative reticulocytopenia.101 Jaundice and hepatosplenomegaly may be present. Nonhematologic manifestations include poor growth and syndactyly of the fingers or toes. Marrow examination shows megaloblastoid erythroid hyperplasia, distinct chromatin bridges between erythroid cells, and binucleated normoblasts. Inheritance is autosomal recessive due to mutations in most cases in condanin-1, CDAN1, or rarely CDIN1. In a few cases, the genetic cause is unknown. Treatment includes supportive care, interferon administration, and in severe cases, HSCT. Iron overload may occur.
Type II CDA is characterized by moderate to severe macrocytic anemia with relative reticulocytopenia.102 Presentation in the neonatal period with anemia and jaundice occurs in about one-quarter of cases. In childhood, jaundice, hepatosplenomegaly, and gall stones are common. Nonhematologic manifestations are rare. Marrow examination shows marked bi- and multinucleated erythroblasts (Figure 7). Marrow iron is typically increased. Inheritance is autosomal recessive due to mutations in SEC23B, a protein involved in vesicle transport. Treatment includes supportive care, splenectomy, and in some cases, HSCT. Significant iron overload often requires therapy.
Type III CDA, like type II, is characterized by moderate to severe macrocytic anemia with relative reticulocytopenia. Nonhematologic manifestations include a hair-on-end appearance on a skull radiograph. Marrow examination shows multinuclear erythroblasts, even gigantoblasts (up to 12 nuclei). Inheritance is autosomal dominant due to mutations in KIF23, a member of the kinesin-like protein family.103 Treatment includes supportive care. Iron overload may require therapy. Affected patients have an increased prevalence of lymphoproliferative disorders in adulthood. An autosomal recessive form of CDAIII without skull defects due to mutations in RACGAP1, the partner of MKLP1 in the centralspindlin complex, has recently been described.104
Several variant CDAs have been described. X-linked anemia and thrombocytopenia presenting in utero or in the neonatal period due to defects in the transcription factor GATA1 have been described.105 Marrow examination shows severe dyserythropoiesis. Severe anemia presenting in utero or the neonatal period due to a mutation in the transcription factor KLF1 has been described. Affected patients have severe hemolysis, ineffective erythropoiesis, elevated HbF, and alterations in many membrane proteins, including those carrying various blood group antigens. CDA with anemia, extramedullary erythropoiesis, dysmorphic features, skeletal anomalies, cholestatic liver disease, diarrhea, and poor growth presenting in the neonatal period has been described in patients with mevalonate kinase deficiency.106 CDA presenting in infancy with exocrine pancreatic insufficiency and calvarial hyperostosis has been described due to mutations in COX4I2, a component of the cytochrome c oxidase complex.107
CDA with neurodevelopmental delay due to mutations in the VPS4A gene, which encodes an ATPase involved in regulating endosomal protein sorting.108
BM replacement syndromes
Anemia can develop as a secondary effect of infiltration of the BM by cells not typically found in the marrow, such as leukemia, metastatic cancer, particularly neuroblastoma in pediatric patients (Figure 7), granulomatous lesions, storage diseases such as mucopolysaccharidosis type VII, or myelodysplasia and myelofibrosis. Laboratory findings including pancytopenia, relative reticulocytopenia, normoblasts and red cell teardrops, giant platelets, and immature leukocytes are seen on PB smear. BM examination shows infiltration by the invading cancer, granulomatous disease, abnormal storage cells, or fibrosis.
Transient myeloproliferative disorder (TMD)
Unique to infancy, TMD is characterized by the proliferation of myeloblasts in the liver, marrow, and blood mimicking congenital leukemia, typically in patients with trisomy 21.109 Anemia and thrombocytopenia are common. In contrast to congenital leukemia, spontaneous remission occurs in most cases. However, after remission, ∼20% of patients will later develop acute myeloid leukemia.
Osteopetrosis
Osteopetrosis syndromes are a group of rare, inherited skeletal disorders characterized by increased bone density and abnormal bone growth. Clinical findings are heterogeneous, ranging from neonatal onset with life-threatening complications to incidental findings identified on chest radiograph in an adult. At least 10 genes have been implicated with varying patterns of inheritance and clinical severity. The recessively inherited, malignant form of osteopetrosis presents in the neonatal period with craniomegaly, bony sclerosis, hepatosplenomegaly, and abnormalities of hematopoiesis, including progressive anemia. Failure of osteoclasts to resorb and remodel bone leads to progressive obliteration of the BM cavity. This leads to extramedullary hematopoiesis in the spleen and liver and gradually worsening macrocytic anemia with reticulocytosis.110 Many patients with malignant recessive osteopetrosis become transfusion-dependent. Hypersplenism may contribute to anemia, thrombocytopenia, and neutropenia. Treatment is HSCT.111
Myelodysplastic syndromes (MDSs)
MDSs in children are a rare, heterogeneous group of clonal disorders which, in contrast to adults, rarely exhibit refractory anemia and ringed sideroblasts and are rarely associated with -del(5q) chromosome.112 Similarly, whereas adults frequently present with isolated macrocytic anemia, children may present with cytopenias including macrocytic anemia, thrombocytopenia, neutropenia, as well as elevated HbF.113 Pediatric MDSs are associated with inherited BM syndromes, previous exposure to cytotoxic agents including alkylating agents and topoisomerase inhibitors, and genetic germline predisposition.114 Genes associated with MDS in adults such as TET2, DNMT3A, TP53, and spliceosome complex mutations are not linked to pediatric MDS but instead are associated with somatic driver mutations in Ras pathway genes, SETBP1, GATA2, RUNX1, ASXL1, and RAS oncogenes.115 Germline mutations in GATA2, ETV6, SRP72, and SAMD9/SAMD9-L predispose individuals to MDS or acute myeloid leukemia. Treatment regimens are complex, but many involve HSCT.113
Infectious suppression
In addition to hemolysis, infection may lead to BM suppression with resultant cytopenias. Infectious suppression has been associated with several viral infections, including parvovirus B19, human immunodeficiency virus, Epstein-Barr virus, CMV, hepatitis A, B, C, and E, and T-cell leukemia-lymphoma virus. It has been described in patients with tuberculosis, streptococcal infections, and those with overwhelming sepsis. In some cases of infection there may be hemolysis along with marrow suppression, particularly in malaria and CMV infection.
Parvovirus B19 infection is a significant cause of anemia in susceptible patients.116 Parvovirus B19 is the cause of the common childhood illness, erythema infectiosum, also known as Fifth disease, characterized by fever, chills, vomiting, and diarrhea, and a maculopapular exanthem on the face mimicking “slapped cheeks” which appear with the resolution of the fever. During infection, parvovirus B19 selectively infects erythroid precursors and inhibits their growth, leading to an acute decrease in Hb and reticulocytopenia, which gradually resolves. This drop in Hb is tolerated by normal children and adults. However, in patients with chronic hemolysis and shortened erythrocyte life span, such as those with inherited hemolytic anemias, interruption of erythropoiesis leads to acute anemia with reticulocytopenia that can lead to significant symptomatology, including cardiovascular compromise and death. Treatment for this group of patients is supportive. Another susceptible host is the fetus, who may acquire infection from the mother. Serial in utero transfusions may be necessary. Chronic anemia due to persistent parvovirus B19 infection may occur in patients with compromised immune systems due to inherited or acquired causes. Treatment may include transfusion, adjustment of immune-modulating medications, or immunoglobulin (IVIG).
Medication- or toxin-induced suppression
BM suppression is associated with the administration of numerous medications, particularly chemotherapeutic and antineoplastic agents and medications affecting the immune system. Other implicated medications include azathioprine, chloramphenicol, meclofenamic acid, phenylbutazone, quinidine, trimethoprim-sulfadiazine, and albendazole. Anticonvulsant medications, particularly carbamazepine, phenytoin, and valproic acid, have been associated with an aplastic anemia-like picture. In most cases, effects are dose-related, and marrow recovery is seen after discontinuation of the offending agent. In a few cases, treatment with recombinant human erythropoietin led to erythroid hypoplasia with a hyporegenerative anemia due to the production of antierythropoietin antibodies.
Toxic chemicals found in various preparations such as pesticides and insecticides, arsenic found in contaminated groundwater, and benzene found in gasoline have been linked to aplastic anemia and/or marrow suppression.
Copper deficiency
Copper deficiency may be caused by inadequate intake as occurs in anorexia nervosa, malnutrition, vegan diets, parenteral nutrition, and postpyloric feeds, increased demand as occurs in pregnant or lactating women and growing premature infants, abnormal copper metabolism as occurs in Menkes disease and familial hypoceruloplasminemia, and inadequate absorption or increased loss in inflammatory bowel disease, Crohn’s disease, celiac disease, and recently after bariatric surgery.117 Copper deficiency has neurologic and hematologic manifestations.118 Neurologic findings mimic subacute combined degeneration, myeloneuropathy, and optic neuropathy. Hematological manifestations include anemia, sometimes with neutropenia and thrombocytopenia.119 Similar to myelodysplasia, marrow examination shows dysplastic erythroid precursors with ring sideroblasts, nuclear budding, and multilobulation. Unlike MDS, copper-deficient marrow demonstrates cytoplasmic vacuolization in erythroid and myeloid cells. Hematologic findings are reversible with copper supplementation, whereas neurological manifestations are only partially reversible.
Other causes
Thyroid disorders
Macrocytic and normocytic anemias have been described in patients with hypothyroidism. Additional findings include, in some cases, anisocytosis and acanthocytes on PB smear. Anemia corrects with the treatment of hypothyroidism. Population studies indicate anemia is common in patients with both hyperthyroidism and hypothyroidism.
Splenic sequestration
Several disorders are associated with significant splenomegaly, which may lead to hypersplenism and pancytopenia. A combination of hemolysis, sequestration, and premature destruction of blood cells contributes to pancytopenia. BM examination reveals normal cell number and proliferation. When pancytopenia is caused by splenic sequestration, splenectomy may be curative.
Macrocytic anemia with increased reticulocyte count
Active hemolysis with brisk reticulocytosis is the most common etiology of macrocytic anemia with elevated reticulocyte count.
Conclusions
Anemia is a commonly encountered problem in pediatrics. There is a broad differential diagnosis that can be narrowed by careful review of the patient’s and family’s history, physical examination, and laboratory testing. Knowledge and application of appropriate treatment strategies will allow for the best outcome.
Acknowledgments
This work was supported in part by grants 5P01DK032094, RO1DK111539, and 5R01DK104046 from the National Institutes of Health, National Institute of Diabetes and Digestive and Kidney Diseases.
Authorship
Conflict-of-interest disclosure: The author declares no competing financial interests.
Correspondence: Patrick G. Gallagher, Departments of Pediatrics, Pathology, and Genetics, Yale University School of Medicine, 333 Cedar St, PO Box 208064, New Haven, CT; e-mail: patrick.gallagher@yale.edu.

This feature is available to Subscribers Only
Sign In or Create an Account Close Modal